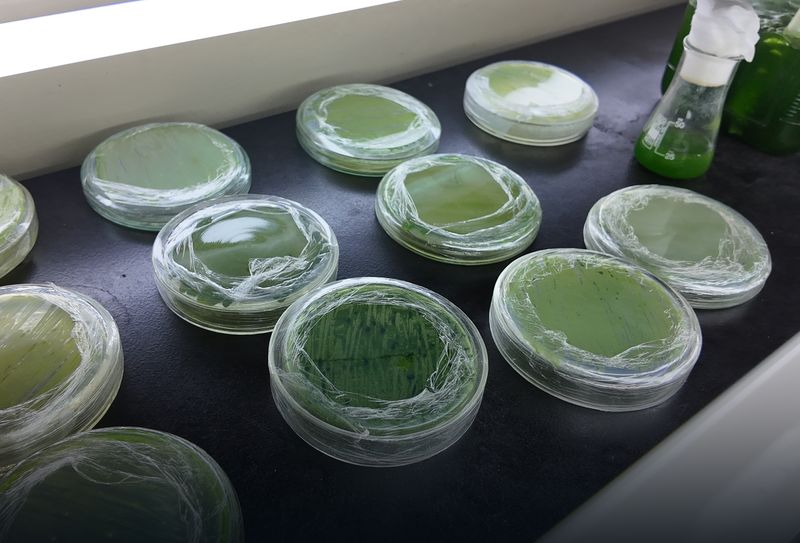
QUÍMICA

Descubre nuestros laboratorios de clase mundial
Explora más de 47 laboratorios especializados equipados con tecnología de punta. Encuentra el espacio perfecto para tu formación profesional.
Espacios equipados con tecnología de punta para tu formación profesional